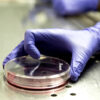

The patent is the juridical instrument allowing everyone has realized an invention to get the exclusive right to produce and sell it in the State where the patent has been applied for (art. 1 L.I.). CELSUS Studio “Patent Office”, offers inventors and interested firms full assistance. As a matter of fact, our office can realize detailed descriptions of the object to be patented, Technical drawings on the AutoCAD or similar programs, and, for those who have created ideally an object, without having an idea of how to project and then build it, the “engineerization”.
The latter consists of the study of the object in matter and the drafting of a detailed description of the idea, equipped with many drawing tables; finally, once the project has been realized and patented, we’ll proceed with the Advertising Management of the patent in order to sell it. Having a project or a patent “engineerized” virtually means to introduce yourselves to firms with professionalism, showing at best your idea. Obviously, firms hardly consider incomplete projects or patents without any related serious feasibility study.
Normally, projects are delivered on paper, perfectly bound, and on magnetic support; but today, thanks to Internet, this extraordinary means of communication spread during last years, projects may be delivered even by e-mail. Nowadays, the patent is the heart of innovation for big firms. For this reason, resort to this kind of protection is highly recommended by experts all around the world, since it is an incredible opportunity for aggressive economies like the US and the European ones, and even for other developing economies like the Japanese and Asian ones, which made and make of innovation their strong point in the world market.